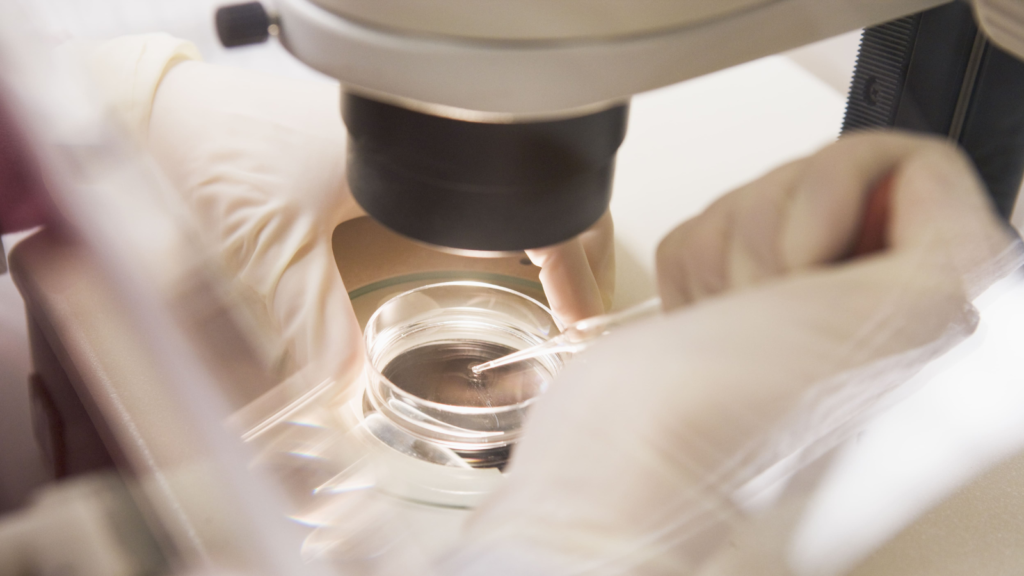
シリンジ法で40代の妊娠成功率を上げる方法とその効果

自宅でチャレンジできる妊活の一つにシリンジ法があります。性交渉をしない妊活であるため「排卵日付近になるとプレッシャーを感じてしまう」「お互いのタイミングがあわず性交渉の回数が少ない」といった夫婦にとっては、興味深い方法ではないでしょうか。
この記事では、シリンジ法の適応やメリット、40代での妊娠成功率などについて解説します。
シリンジ法とは何か?
シリンジ法とは、針のない注射器(シリンジ)に入れた 精液 を 膣内 に注入することで、精子 と 卵子 を 受精 させる方法です。
シリンジ法では、女性の排卵期にあわせて、男性が自分で精液を採取します。採取した精子をシリンジで膣内に注入することにより、性交渉をしなくても精子と卵子を受精させることができるのです。
シリンジ法は専用キットを使用し、自宅で実施できます。キットは通信販売で入手することが可能ですが、不妊治療外来のある病院などでも購入できます。
シリンジ法が適している人は?
手軽に挑戦できるシリンジ法ですが、すべての人に有効な方法ではありません。シリンジ法が向いているのは、以下のようなケースです。
- ・性交痛 や 勃起障害 、射精障害などにより性交渉が困難である
- ・タイミングがあわず、排卵期に性交渉をすることが難しい
- ・妊娠の確率を上げるためにさまざまな方法を試してみたい
- ・妊活に伴う心身の負担や、経済的な負担を少しでも減らしたい
一方で、「精子の運動率が低い」「月経周期が乱れている」といった人には向かない可能性があります。
シリンジ法の利点
子どもを望む夫婦にとって、シリンジ法による妊活にはさまざまなメリットがあります。
- ・性交渉をしなくても妊娠できる可能性がある
- ・排卵日にあわせて性交渉をするプレッシャーから解放される
- ・自宅で手軽に妊活を始められる
- ・1回あたり500円程度と費用が安い
- ・タイミング法や 体外受精 など、他の妊活や不妊治療と併用できる
タイミング法の場合、排卵日の前後で3回ほどタイミングをとるように指導されるでしょう。
しかし、排卵日にあわせて性交渉をすることにプレッシャーを感じてしまったり、仕事の都合などでタイミングをとることが難しかったりする場合もありますよね。
シリンジ法であれば、「3回のうち1回はシリンジ法にする」といった方法を選択できるため、妊活に伴うお互いの負担を減らすことができます。

シリンジ法の実践方法
シリンジ法を行うときには、キットに添付されている説明書を必ず確認しましょう。ここでは、シリンジ法を実践するときの、一般的な手順とポイントについて説明します。
セルフシリンジのステップとコツ
シリンジ法の実施手順は、大きく二つのステップに分かれます。
- 1.精液の採取
まずはマスターベーションにより精液を採取します。採取前には手洗いをして、手指を清潔にしておきましょう。精液を採取する際には、キットに付属している精採容器を使用します。採取した精液は、透明な液状になるまで5〜10分程度放置します。
- 2.精液の注入
手指をよく洗って清潔にし、シリンジを取り出します。採取した精液が透明になっていることを確認したうえで、シリンジで精液を吸い上げましょう。
次に、シリンジの先端を上方に向けて、空気が入っていないことを確認します。空気が入っている場合には、ゆっくりとシリンジの押し子を押して空気を抜きましょう。
最後にシリンジを膣内に入れて、ゆっくりと精子を注入します。注入後は、速やかにシリンジを膣から抜きましょう。
カテーテルと呼ばれる、シリコン状の管が付属しているキットを使用するときには、シリンジにカテーテルを接続して精液を吸い上げ、膣内に注入します。
シリンジ法を成功させるためのポイント
十分な精子の量を確保できるよう、とくに排卵日近くは規則正しい生活を心がけましょう。精液の量や質は、疲労やストレス、食生活などによる影響を受ける可能性があります。
しっかりと睡眠をとって体を休めたり、脂質の多い食事を控えたりすることが効果的です。
また、なるべく新しい精子を採取できるよう、シリンジ法を行う4〜5日前に一度射精しておくと良いでしょう。精液が少なく心配な場合には、撥水性のあるシート状の採精容器が付属した商品を使用するのも一つの方法です。
また、女性側は精子を注入した後、しばらく安静を保つことが大切です。注入後10〜15分程度は、リラックスした姿勢で過ごしましょう。

シリンジ法の成功率とリスク
シリンジ法の成功率やリスクについて、国内には関連する研究が少なく、まだ明らかになっていないことも多いのが現状です。
40代の妊娠成功率に与える影響
海外の外来不妊治療クリニックで行われた調査研究によれば、未完成婚(ある一定期間、定期的な性交渉を試みても陰茎と膣の貫通に至ることができない障害)のカップルに対してシリンジ法を実施したところ、下記のような妊娠率を得たと報告されています。
調査では、1回の排卵期を1サイクルとして、排卵予定日前後1日おきに自宅でシリンジを用いた膣内授精を6サイクル実施した場合の妊娠率と、1サイクル毎の妊娠率を測定しています。
・女性20〜33歳のグループ:妊娠率68.9%(1サイクル毎の妊娠率23.3%)
・女性33〜36歳のグループ:妊娠率42.8%(1サイクル毎の妊娠率13%)
・女性36〜40歳のグループ:妊娠率25.0%(1サイクル毎の妊娠率4.3%)
※ここでの妊娠率は、「尿の妊娠検査で陽性判定」が出た割合を示します。
(参考:結婚が成立していないカップルにおける自宅膣内授精の妊娠結果)
シリンジ法によって妊娠する確率は、タイミング法とほぼ変わらないと考えられています。シリンジ法と他の方法を併用することによって、妊娠の確率が高まることが期待できるでしょう。
引用元)結婚が成立していないカップルにおける自宅膣内授精の妊娠結果(2017)
シリンジ法のリスクと注意点
医師や助産師の指導がなくてもチャレンジできるシリンジ法ですが、実施する際には以下の点に注意しましょう。
- ・専用キットをインターネットで購入する際には、一般医療機器として登録されている安全性の高い商品を使います。不安な場合は、キットを取り扱っている病院で購入すると良いでしょう。
- ・専用キットは使用直前に開封し、不衛生にならないよう取り扱いに注意します。
また、一度使用したキットを繰り返し使うことは避けましょう。膣内で細菌感染を起こすなど、トラブルにつながるおそれがあります。 - ・シリンジやカテーテルを膣内に挿入した際、痛みがあった場合はすぐに使用を中止してください。使用を中止しても痛みが続くときや、赤みや痒みなどの皮膚症状が出たときには、医師に相談しましょう。
- ・不妊治療とシリンジ法を併用する場合には、事前に主治医へ相談しましょう。
例えば、人工授精の前日にシリンジ法を行うために 射精 してしまうと、精液 の状態が悪くなってしまう可能性があります。
他の妊娠方法との比較
妊活や不妊治療にはさまざまな方法があるため、「シリンジ法と他の妊娠方法との違いがよくわからない」という人もいるでしょう。しかし、シリンジ法は、人工授精 や 体外受精 とはまったく異なるものです。
人工授精や体外受精との違い
シリンジ法と人工授精・体外受精では、精子の採取方法や、精子を注入する部位が異なります。
人工授精では採取した精子を一度洗浄して、運動性の良い精子だけを選んで子宮腔内に注入します。受精 が成立する卵管膨大部に、十分な量の精子を届けることができるため、精子の運動率が低い場合にも選択できる治療法です。
また、体外受精では排卵直後の卵子を手術によって取り出し、体外で精子と受精させます。受精卵が得られたら、数日間培養して子宮に移植します。
卵管に障害があったり、不妊の原因がわからなかったりするケースにも適応される治療法です。
シリンジ法が選ばれる理由
厚生労働省の調査によれば、夫婦全体の約4.4組に1組は、不妊の検査や治療を経験しています。さらに、不妊治療をしたことがある(または予定している)労働者のうち「不妊治療と仕事の両立ができなかった(または両立できない)」という労働者の割合は、全体の34.7%を占めています。
晩婚化や共働き世帯の増加が進むなか、「子どもを授かりたいけれどタイミングがあわない」「早く子どもを授かるためにさまざまな方法を試したい」といった夫婦もいるでしょう。
このような背景から、性交渉や通院が不要であり、不妊治療とも併用できるシリンジ法が選ばれているのではないでしょうか。
引用元)厚生労働省「不妊治療と仕事との両立サポートハンドブック」P.3
助産師より

シリンジ法は、性交渉が難しい人や、うまくタイミングがとれず妊活にストレスを感じている人にも取り組みやすい方法です。とくに、年齢を意識して焦りを感じやすい40代の妊活では、選択肢が一つでも多い方が安心ですよね。
しかし、不妊の原因によっては、シリンジ法だけでは妊娠が難しいこともあります。「シリンジ法を何度か試したけれど結果が出ない」といった場合には、早めに医師へ相談しましょう。
